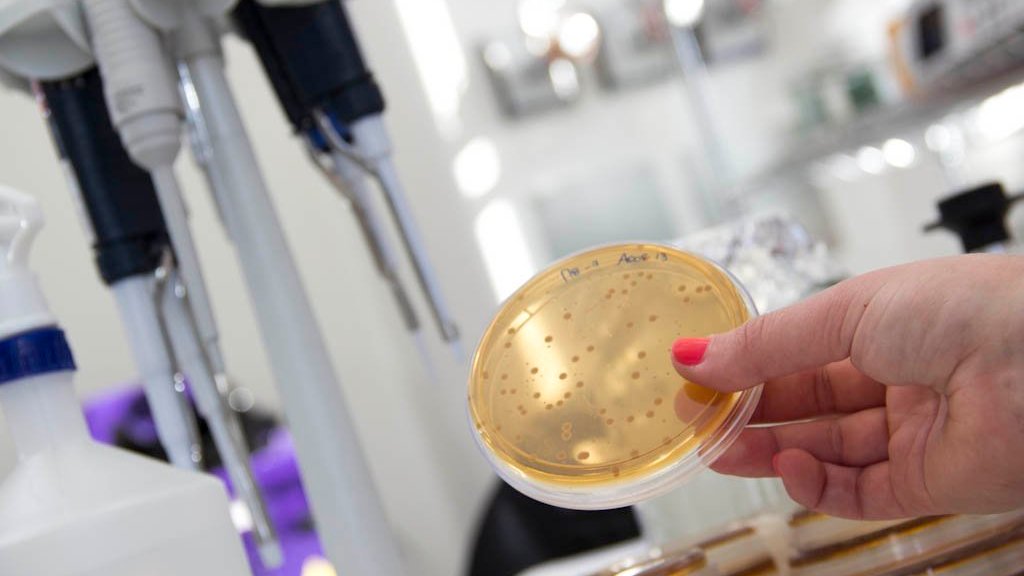

Últimas Entradas
Estrecho de Ormuz: en 24 horas abierto, condicionado y otra vez cerrado
Los últimos acontecimientos en el estratégico estrecho mantienen al mundo en vilo.En menos de un día, el estrecho de OrmuzSeguir leyendo
Análisis. Las vacancias de la ley electoral bonaerense
A 80 años de su sanción y ante la posibilidad de un nuevo desdoblamiento electoral en la Provincia de BuenosSeguir leyendo
La Circulación Meridional de Vuelco del Atlántico se está debilitando más rápido de lo previsto y podría acercarse a un punto crítico a finales de este siglo, según una nueva investigación.
El colapso de este sistema de corrientes se acerca y amenaza con desatar catástrofes globales El sistema esencial de corrientesSeguir leyendo
ARGENTINA. La vida no vale nada: Sturzenegger elimina controles y pone en riesgo la salud de los argentinos
El ministro dio de baja cerca de mil servicios que prestaba el instituto a muy bajo costo. “No existen laboratoriosSeguir leyendo
Argentina. CABA. Cine solidario por Gaza: proyectan “La Voz de Hind Rajab” en un encuentro de memoria y compromiso
Este viernes 17 de abril a las 19 horas, en Av. Medrano 629, se realiza una jornada de cine solidarioSeguir leyendo
MIRADAS. A orillas de Ormuz: El albor de un nuevo orden mundial, tras las huellas de Suez 1956
El fracaso de la agresión contra Irán supondrá un declive de la hegemonía estadounidense y el surgimiento de potencias queSeguir leyendo
Argentina. AMBA. Morón. El Peronismo Ghiista volvió a mostrarse en Público
Este miércoles 15, en el Centro de Industriales Panaderos, el intendente Lucas Ghi realizó los festejos de «su» peronismo, alSeguir leyendo
GUERRA CON IRÁN. EE.UU. lanza advertencia petrolera a China
«No van a poder obtener» el petróleo iraní, aseveró Scott Bessent. El secretario del Tesoro de EE.UU., Scott Bessent, aseguró este martesSeguir leyendo
ARGENTINA. La UBA sale a la calle: clases públicas y servicios gratuitos para exigir el financiamiento universitario
Las facultades de la Universidad de Buenos Aires realizarán este miércoles una jornada de visibilización de 24 horas en PlazaSeguir leyendo
Argentina. Congreso. Segunda oportunidad para hogares endeudados: el proyecto que busca frenar embargos y reestructurar deudas
Diputadas de Unión por la Patria presentaron una iniciativa que propone un sistema administrativo, gratuito y obligatorio para renegociar deudasSeguir leyendo
Miradas. Argentina. AMBA. Morón. ¿Puede revivir la disputa Sabbatella / Zabaleta?
La sugerente pregunta realizada públicamente por el periodista Adrián Noriega en su programa Primer Plano, sobre si Juan Horacio «Juanchi»Seguir leyendo